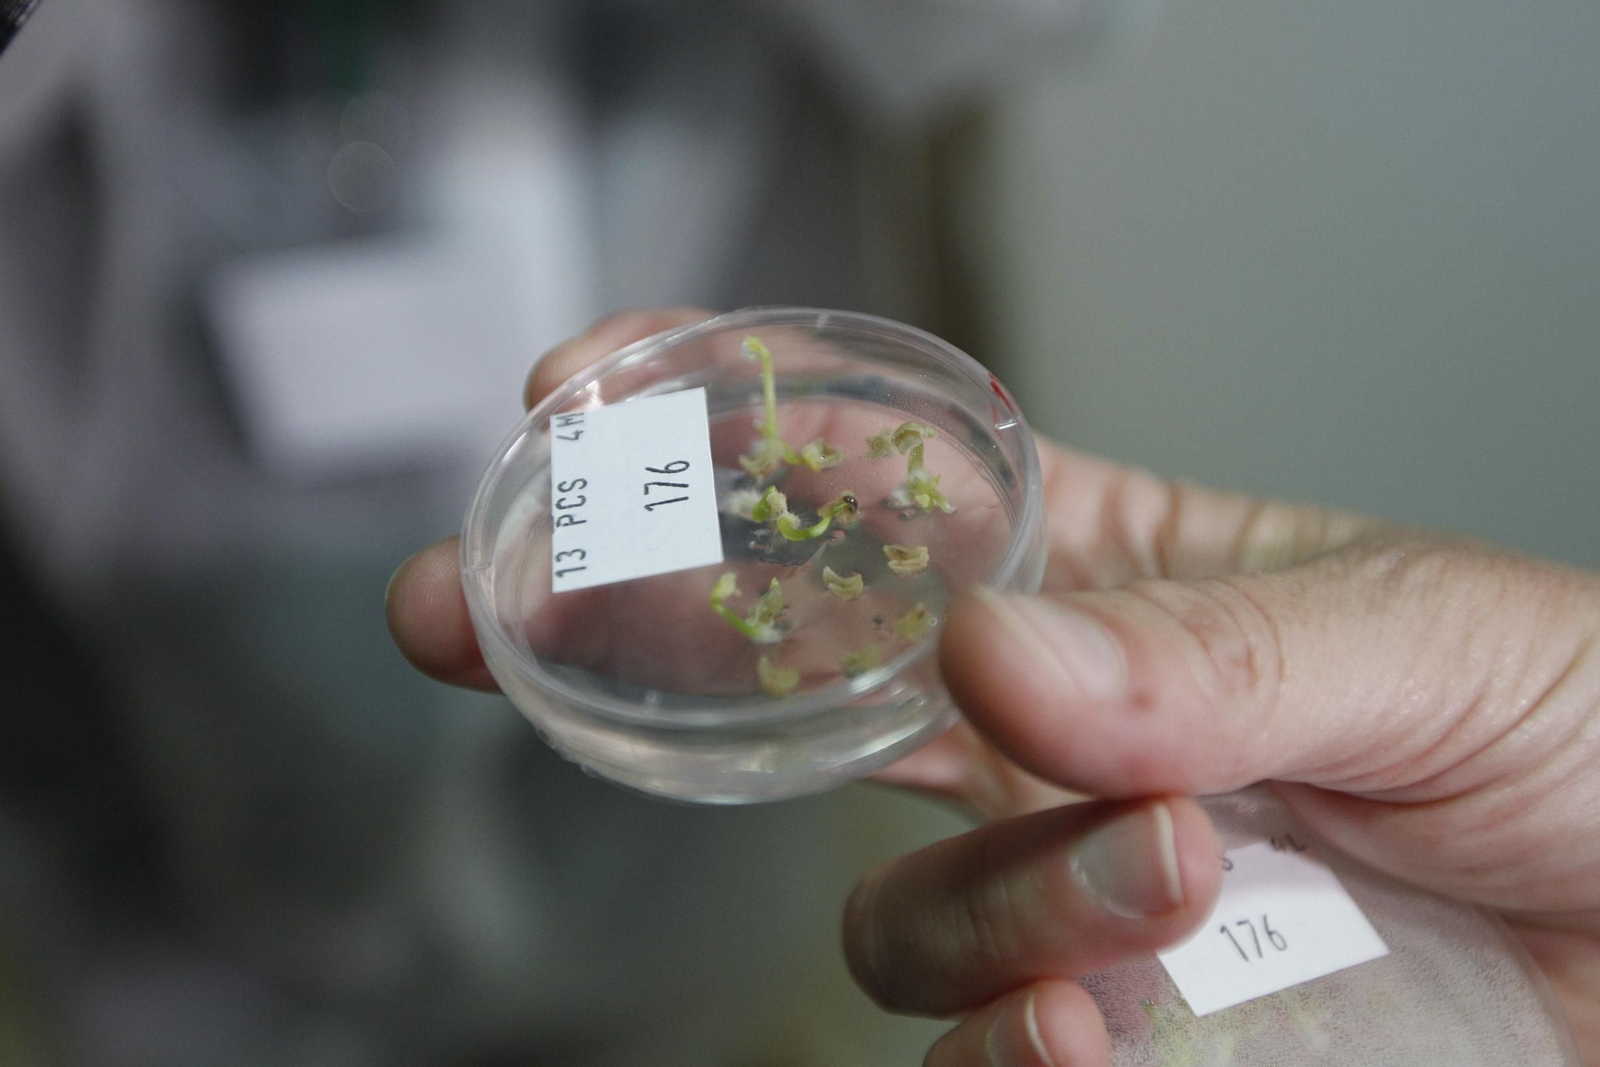
Fotogalería presentación resultados Bayer

Fotogalería presentación en Almería resultados Bayer Iberia
La multinacional Bayer ha presentado, en sus instalaciones de La Mojonera (Almería), los resultados de la región Iberia (España y Portugal) correspondientes a 2018. (Fotos Javier Alonso)

También te puede interesar
Lo último